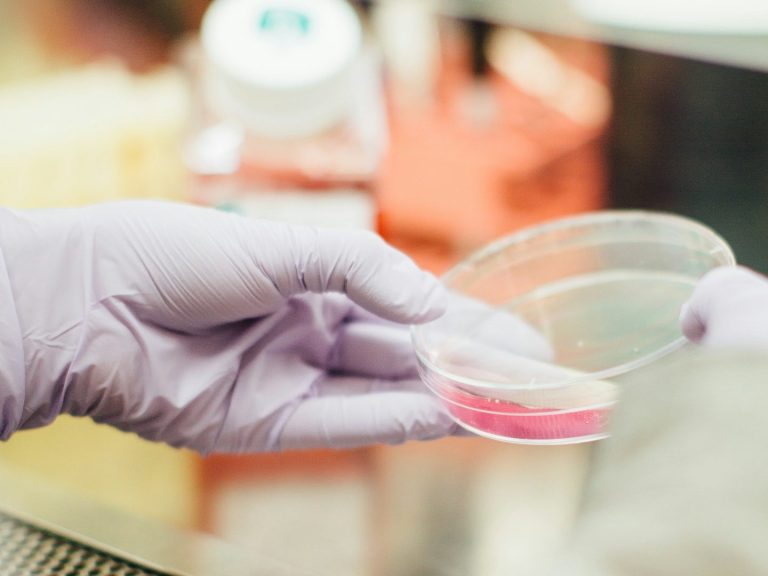

At Clinexa, we provide high-quality, independent medical reports to support personal injury claims—specialising in soft tissue and psychological injuries.
Your trusted partner in independent medical evidence
At Clinexa, our experts compile comprehensive medical legal reports tailored to your needs.
We focus on providing independent assessments for various injury types including soft tissue and psychological injuries.
Our commitment is to uphold the highest standards in reporting.

Reports Completed
Qualified Experts
Years of Experience
Our expertise spans across multiple domains, ensuring that you receive top-notch reports.
Explore the highlights of our offerings and why we are the leading choice in medical legal reporting.

Specialized reports addressing specific soft tissue injuries with clarity and precision.
Expert evaluations for psychological injuries, delivered by seasoned professionals.

Comprehensive reports conducted by orthopaedic specialists to support your case.

A panel of experienced experts ready to collaborate for thorough assessments.
Telephone: 0207 566 1194
E-mail: info@clinexa.org
Address: 124 City Road, London, EC1V 2NX, United Kingdom
©Copyright. All rights reserved.
We need your consent to load the translations
We use a third-party service to translate the website content that may collect data about your activity. Please review the details in the privacy policy and accept the service to view the translations.